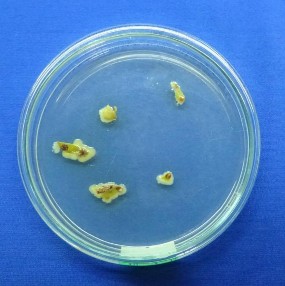
Phân lập mẫu Ria làm thuần mẫu 1 3 Hình ảnh chủng bệnh nhân tạo trong phòng 1
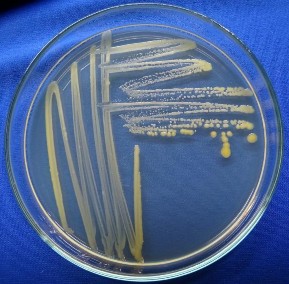
Phân lập mẫu Ria làm thuần mẫu 1 3 Hình ảnh chủng bệnh nhân tạo trong phòng 2
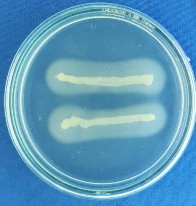
Thủy phân casein Thủy phân Tween 80 Thủy phân tinh bột 1 5 Hình ảnh mẫu cây giao 15

Sci.) 37: 445-452.
147. Wang L., Yu M-M., Chi Y-Q., Quyang W-B., Zang Z. and Zhao Y., 2014. Chemical constituents of Euphorbia dracunculoides. China Journal of Chinese material medica, 39(20): 3969-3973.
148. Waterman P.G. and Mole S.,1994. Analysis of phenolic plant metabolites. Oxford, UK: Blackwell Science, 248p
149. Xue J., Davidson P.M. and Zhong Q., 2013. Thymol nanoemulsified by whey protein-maltodextrin conjugates: the enhanced emulsifying capacity and antilisterial properties in milk by propylene glycol. J. Agr. Food Chem. 61: 12720-12726.
150. Yadav R., Srivastav K., Ramesh C. and Singh A., 2002. Larvicidal activity of latex and stem bark of Euphorbia tirucalliplant on the mosquito culex quinquefasciatus. J. communicable dis. 34: 264-269.
151. Yang Y. and Gabriel D.W., 1995. Xanthomonas avirulence/pathogenicity gene family encodes functional plant nuclear targeting signals. Mol. Plant-Microbe Interact. 8: 627-631.
152. Yoshida T., Yokoyama K., Namba O. and Okuda T., 1991. Tannins and related polyphenols of euphorbiaceous plants: VII, Tirucallins A, B and euphorbin F, monomeric and dimeric ellagitanninsfrom Euphorbia tirucalli L, Chem. Phar. Bull. 39: 1137-1143.
153. Younes A.B., Salem M.B., Abed H.E. and Jarraya R., 2018. Phytochemical Screening and Antidiabetic, Antihyperlipidemic,and Antioxidant Properties of Anthyllis henoniana (Coss,) Flowers Extracts in an Alloxan-Induced Rats Model of Diabetes. Evidence-Based Comple. Alter. Medici. 3: 1-14.
154. Yusoff E., Ahmada A., Mohamada S. and Muhamma N.F., 2017. GC-MS analysis of some volatile constituents extracted from stem of Euphorbia tirucalli Linn. Arch. Oro. Sci. 12(1): 36-44.
Có thể bạn quan tâm!
-
Hiệu Quả Phòng Trừ Bệnh Loét Trên Cây Chanh Của Cao Ea Ở Các Nồng Độ Khác Nhau Trong Điều Kiện Nhà Lưới -
Nghiên cứu khả năng ức chế vi khuẩn Xanthomonas sp. gây bệnh loét trên cây chanh của cao chiết phân đoạn từ cây Giao Euphorbia tirucalli L. - 17 -
Nghiên cứu khả năng ức chế vi khuẩn Xanthomonas sp. gây bệnh loét trên cây chanh của cao chiết phân đoạn từ cây Giao Euphorbia tirucalli L. - 18 -
Kết Quả Đặc Điểm Sinh Hóa Của 75 Mpl Được Phân Lập Ở Long An -
Kết Quả Kích Thước Trung Bình Vết Bệnh Của Các Mpl Sau Chủng Bệnh -
Kết Quả Đăng Ký Trình Tự Vùng 16S Rdna Trên Genebank Của 9 Mpl Xanthomonas Sp.
Xem toàn bộ 232 trang tài liệu này.
155. Zarai Z., Emna B., Nadia B.S., Youssef G. and Adel S., 2013. Antioxidant and antimicrobial activities of various solvent extracts, piperine and piperic acid from Piper nigrum. LWT-Food Sci. Technol. 50: 634-641.
156. Zhishen J., Mengcheng, T. and Jianming, W., 1999. The determination of
flavonoid contents in mulberry and scavenging effects on superoxide radicals. Food Chem. 64: 555-559.
PHỤ LỤC
PHỤ LỤC 1. MỘT SỐ HÌNH ẢNH THÍ NGHIỆM TRONG LUẬN ÁN
1.1. Vườn chanh thu mẫu ở ba huyện Bến Lức, Thạnh Hóa và Đức Huệ
A
B
C
Hình 1.1. Các vườn chanh thu mẫu ở ba huyện Bến Lức, Thạnh Hóa và Đức Huệ
(A: Bến Lức; B: Thạnh Hóa; C: Đức Huệ)
1.2. Hình ảnh phân lập và làm thuần vi khuẩnXanthomonas sp. từ các mẫu bệnh được thu nhận

Phân lập mẫu Ria, làm thuần mẫu
1.3. Hình ảnh chủng bệnh nhân tạo trong phòng thí nghiệm theo quy tắc Koch’s


Chủng bệnh trên lá Chủng bệnh trên cành

Chủng bệnh trên quả
1.4 Hình ảnh khảo sát đặc điểm sinh hóa của các MPL Xanthomonas từ cây chanh có biểu hiện bệnh loét ở Long An


Nhuộm Gram Chụp SEM



Thử nghiệm catalase Thử nghiệm oxidase Thử nghiệm KOH 3%



Khả năng phát triển trong điều kiện kỵ khí
Thủy giải gelatinase Thủy phân Urea

Thủy phân casein Thủy phân Tween 80 Thủy phân tinh bột
1.5. Hình ảnh mẫu cây giao, bột cây giao, chiết cao phân đoạn từ cây giao


Mẫu Cây giao tươi Mẫu sau khi sấy khô

Mẫu bột cây giao


Chiết cao phân đoạn Cô quay thu cao chiết
1.6. Hình ảnh chủng bệnh trong nhà lưới


Bố trí TN trong nhà lưới Tạo vết thương nhân tạo


Ủ 24 giờ Triệu chứng bệnh sau 3 ngày chủng

Chọn vết bệnh và cố định bằng dây thun

Đo kích thước vết bệnh






